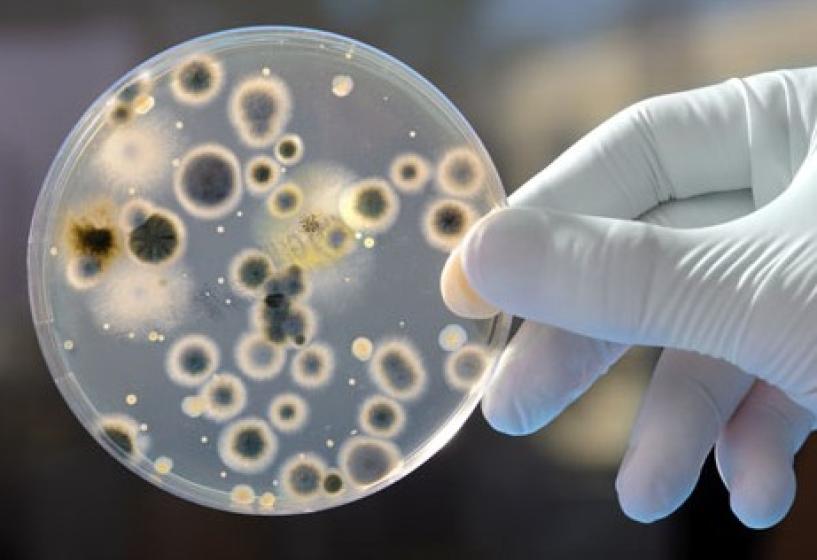

बागलुङको अधिकाँश खानेपानी मुहानमा कोलिफर्म भेटियो, झापखाला हुन सक्ने खतरा
काठमाडौँ । बागलुङको विभिन्न ठाउँको खानेपानी मुहानमा कोलिफर्म भेटिएको छ ।
जिल्लाका दश वटै पालिकाका ३ सय ४१ मुहानको पानी परीक्षण गर्दा १ सय २५ ठाउँमा कोलिफर्म फेला परेको प्रदेश जनस्वास्थ्य कार्यालयले जनाएको छ । प्रायः दिसामा पाइने कोलिफर्म स्वास्थ्यको लागि अत्यन्त हानिकारक जीवाणु हो । कोलिफर्म मिसिएको पानी पिउँदा झापखाला, हैजा, टाइफाइड, जण्डिस, हेपटाइटिस बी, पिसाबको सङ्क्रमण र रगतमा सङ्क्रमण हुन सक्ने चिकित्सकहरु बताउँछन् ।
जिल्लाका विभिन्न पालिका मध्ये जैमिनी नगरपालिकाको मुहानमा सबैभन्दा बढी कोलिफर्म फेला परेको छ । जैमिनीमा १ सय ६ मुहानमा परीक्षण गर्दा ४२ ठाउँमा कोलिफर्म देखिएको छ ।
गलकोट नगरपालिकामा ९१ मुहानमा परीक्षण गर्दा ४० ठाउँमा कोलिफर्म फेला परेको छ । बागलुङ नगरपालिकामा २४ मुहान परीक्षण गर्दा चार र काठेखोला गाउँपालिकामा ४७ मुहान परीक्षण गर्दा २७ स्थानमा कोलिफर्म भेटिएको छ । बडिगाड गाउँपालिकामा ६८ मुहान परीक्षण गर्दा १० ठाउँमा कोलिफर्म देखिएको छ । ढोरपाटन नगरपालिकामा पाँच मुहान परीक्षण गर्दा कुनैमा पनि कोलिफर्म नदेखिएको जनस्वास्थ्य कार्यालयले जनाएको छ ।
निसीखोला, तमानखोला, ताराखोला र बरेङ गाउँपालिकामा भने मुहान परीक्षण गर्न बाँकी छ । जनस्वास्थ्य कार्यालयले अघिल्लो वर्ष खानेपानीका विभिन्न मुहान परीक्षण गर्दा १ सय ३ स्थानमा कोलिफर्म देखिएको थियो । अघिल्लो पटकको परीक्षणमा कोलिफर्म नदेखिएका मुहानमा यस पटक भेटिएको छ । त्यही कारण कोलिफर्म भेटिएका मुहानको संख्या अघिल्लो वर्षको तुलनामा बढेर १ सय २५ पुगेको हो । अघिकाश मुहानमा कोलिफर्म भेटिएपछि पिउने पानीको शुद्धीकरण चुनौतीपूर्ण बनेको छ ।
जनस्वास्थ्य कार्यालयले विभिन्न पालिकालाई ‘वास प्लान’ बनाएर त्यही अनुसार नागरिकलाई सहज रूपमा शुद्ध पिउनेपानीे व्यवस्थापन मिलाउन सुझाव दिएको छ ।














